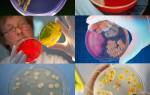

Об эпидемии коронавируса слышал уже каждый. В декабре 2019 года инфекция была обнаружена в Китае (провинция Ухань), а в начале 2020 года начала распространяться по всему миру. Число стран, в которых прогрессирует заболевание, растет, как и количество пациентов. В России по состоянию на 18 марта 2020 года заражено более 100 человек. Рассмотрим, что представляет собой коронавирус, что это за болезнь, как ее распознать и можно ли побороть.
Причины и группы риска
Основные причины возникновения заболевания COVID-19 связаны с проникновением в организм вируса SARS-CoV-2, который начинает размножаться в слизистой дыхательных путей, вызывая характерные симптомы. Больше всего рискуют пожилые люди, лица среднего возраста с ослабленным иммунитетом, беременные женщины. У детей и подростков, как правило, инфекция проходит в легкой форме или вообще без симптомов.
Как передается коронавирус:
- Передача осуществляется преимущественно воздушно-капельным путем – через кашель, чихание.
- В редких случаях отмечен контактный путь передачи.
Врачи отмечают, что коронавирус представляет собой инфекционное заболевание, вызванное вирусом SARS-CoV-2. Основные признаки болезни варьируются от легких до тяжелых и могут включать кашель, одышку, лихорадку, усталость и потерю обоняния. Некоторые пациенты также сообщают о головной боли, болях в мышцах и расстройствах пищеварения. Врачи подчеркивают, что уязвимыми группами являются пожилые люди и лица с хроническими заболеваниями, у которых инфекция может протекать особенно тяжело. Важно своевременно обращаться за медицинской помощью при появлении симптомов, а также соблюдать меры профилактики, такие как вакцинация и ношение масок, чтобы снизить риск заражения и распространения вируса.

Симптоматика
Первые признаки неспецифичны, поэтому распознать в них коронавирус практически нереально. Начало болезни, как и в случае с ОРВИ или гриппом, стандартное – человек страдает от боли в горле, повышается температура. Появляется общая слабость и кашель. Отличительной особенностью симптомов коронавируса можно назвать характер кашля (он очень сухой) и одышку, связанную с легочной недостаточностью, которая проявляется на следующей стадии болезни.
Инкубационный период равен 4-14 дней. Осталось только изучить, как протекает болезнь. Течение болезни индивидуальное, все зависит от особенностей организма. Если он молодой и крепкий, развитие болезни стремительное, как и выздоровление. Если организм старый и ослабленный, течение сложное, есть вероятность летального исхода (3-8%).
Сколько длится коронавирус, тоже определяется индивидуально. Продолжительность болезни, если не присоединились осложнения, составляет до двух недель.
Особенности терапии
Лечение коронавируса симптоматическое: больные принимают препараты, нацеленные на купирование признаков – снижение температуры, устранение дыхательной недостаточности. В случае развития вирусной пневмонии помогает ИВЛ – вентиляция легких. Универсальная вакцина от коронавируса у людей пока не разработана. Однако недавно в Китае завершены клинические испытания препарата Фавилавир (оно ранее применялось от гриппа) на людях, инфицированных коронавирусом. Выяснилось, что лекарство помогает снять жар и другие симптомы, а также ускоряет выработку антител.
Коронавирус, или COVID-19, стал одной из самых обсуждаемых тем последних лет. Люди делятся своими мнениями о болезни, её происхождении и последствиях. Многие отмечают, что симптомы могут варьироваться от легких до тяжелых. Наиболее распространенные признаки включают кашель, лихорадку, усталость и потерю вкуса или обоняния. Некоторые пациенты сообщают о головной боли, болях в мышцах и затрудненном дыхании. Важно отметить, что у некоторых людей болезнь протекает бессимптомно, что делает её особенно опасной. Обсуждения также касаются методов профилактики: ношение масок, соблюдение дистанции и вакцинация стали привычными мерами. В целом, коронавирус изменил наше восприятие здоровья и безопасности, заставив людей более внимательно относиться к своему самочувствию и окружающим.

Профилактические меры
Снизить риск вероятности проявления коронавируса можно так же, как и в случае с ОРВИ, гриппом. Нужно как можно чаще мыть руки и избегать скопления большого количества людей. Запрещено трогать лицо немытыми руками. В рационе должно присутствовать много свежих овощей и фруктов.
Прогноз
Иммунитет после болезни ослабляется, поэтому организму требуется реабилитация – постельный режим и воздержание от посещения людных мест. Болезни, вызываемые коронавирусами, немногочисленны:
- самая опасная – пневмония, которая развивается молниеносно;
- бронхит;
- гастроэнтерит;
- ОРВИ.
Некоторые медики утверждают, что у перенесших эту инфекционную болезнь может развиться бесплодие, однако официального подтверждения этой информации пока нет.
Теперь понятно, что это за болезнь – коронавирус, и можно ли от нее избавиться. Чтобы быть в курсе последних новостей, следите за нашими публикациями.

Вопрос-ответ
Каковы симптомы этого нового вируса?
Симптомы COVID-19: новый, непрерывный кашель — это означает интенсивный кашель, длящийся более часа, или 3 или более эпизодов кашля в течение 24 часов. Потеря или изменение обоняния или вкуса. Одышка. Чувство усталости или истощения.
Какой самый первый признак коронавируса?
Первые симптомы коронавируса: сильная слабость, головная боль, кашель никогда не вызывали столько тревоги, как в период пандемии COVID-19. Его симптомы похожи на проявления обыкновенной простуды, ОРВИ, гриппа, аллергии, поэтому заболевания можно спутать.
Советы
СОВЕТ №1
Следите за актуальной информацией о коронавирусе, обращая внимание на официальные источники, такие как Всемирная организация здравоохранения (ВОЗ) и местные органы здравоохранения. Это поможет вам оставаться в курсе последних рекомендаций и изменений в ситуации.
СОВЕТ №2
Обратите внимание на основные симптомы коронавируса, такие как высокая температура, кашель, одышка, потеря вкуса или обоняния. Если вы заметили у себя или у близких эти признаки, не откладывайте обращение к врачу.
СОВЕТ №3
Соблюдайте меры предосторожности, такие как ношение масок в общественных местах, регулярная дезинфекция рук и соблюдение социальной дистанции. Эти простые действия могут значительно снизить риск заражения.
СОВЕТ №4
Не забывайте о важности вакцинации. Прививки против коронавируса помогают защитить вас и окружающих, снижая вероятность тяжелого течения болезни и распространения вируса.